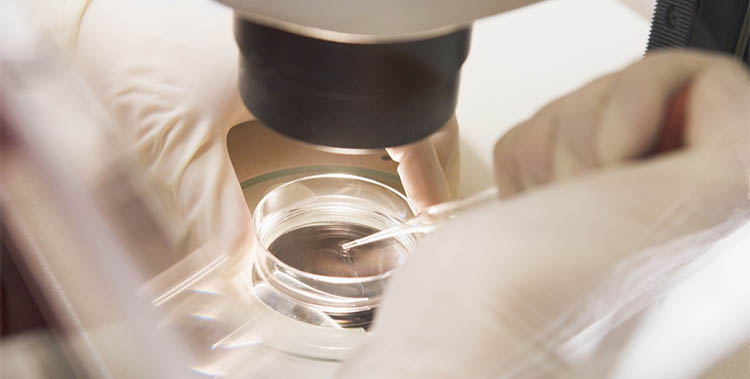

Ovaryan hiperstimülasyondan korunmada yeni stratejiler
Tüp bebek tedavisinde yumurtalıklarda birçok folikülün (yumurtanın içinde bulunduğu su keseciği) geliştirilerek olgun yumurta elde edilmesi amacıyla kontrollü ovaryan hiperstimülasyon...
Devamını Oku →